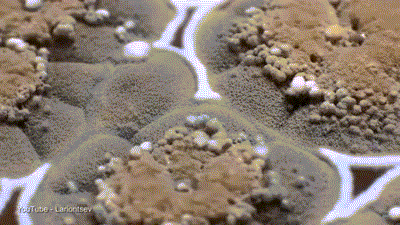
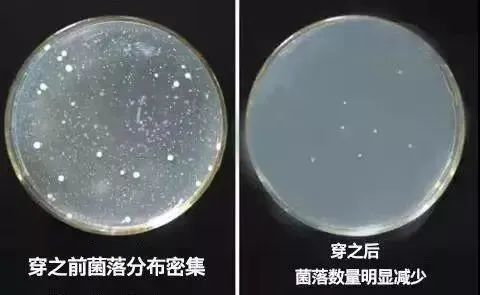

男人内裤的秘密!
2024年02月26日
有个羞羞小秘密
据说男生都懂,但女生不懂
男生下面的设备属于“外挂式结构”
一燥热就会着火、出汗湿黏
堪比温泉煮蛋,非常难受

紧身的感觉本来就很不舒服

可以击菌让你更健康更强壮!









它九个颜色都很MAN

尺码有L-4XL
好产品连尺码都做得很标准,不大不小刚刚好

其他同事觉得内裤夹臀同样困扰,走动弯腰坐下缩成丁字裤,
反手一掏,尴尬!!
















1254阅读
1赞
小来生活馆